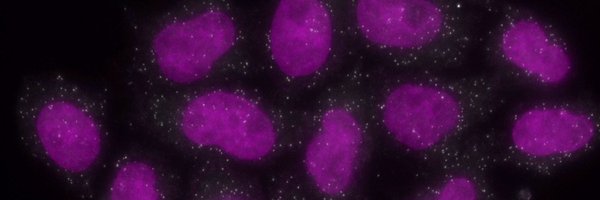
CAMcCormick20 Profile Banner

Caroline McCormick
@CAMcCormick20
Followers
90
Following
263
Media
24
Statuses
173
Retired Bench Scientist║@SRouhanifard Lab Alum║ RNA mods • nanopore sequencing • transcriptome bioinformatics
Boston, MA
Joined October 2021
1/6 🧬New paper at @CellSytemsCP led by @SashaFanari! What if the “fifth nucleotide,” pseudouridine (Ψ), in mRNA dynamically responds to cell state? We used nanopore direct RNA sequencing + Mod‑pID to map Ψ in a neuron‑like SH‑SY5Y line under “normal” and “perturbed” conditions
1
7
25
I never thought I would say this, but I miss R. Excel sucks.
1
1
4
IVT-derived unmodified human transcriptome paper is live! Resource for the #nanopore community. Congrats to the team 🙌🏼 https://t.co/QkgqPUidVp
@CAMcCormick20 @mitenjain @NUBioE1
gigabytejournal.com
Multicellular, IVT-derived, unmodified human transcriptome for nanopore-direct RNA analysis
Preprint alert! Multicellular, IVT-derived, unmodified human transcriptome for nanopore direct RNA analysis. https://t.co/nAUg6SfN6l
2
5
26
Latest preprint from recent grad (!!) @CAMcCormick20 Recently developed nanopore tools have identified psi modifications on mRNAs, but the functions remain unknown. From the list of candidate sites, we need to cull it down to the most interesting 🧵 https://t.co/1gvRz8brIQ
2
8
31
First hooding ceremony as a faculty member—so fun!! Congrats to all grads!!
0
3
42
Congratulations to my first student @SepidehTavakol2, for successfully defending her Ph.D. thesis!! I am so proud of you and all of your hard work!! 🥳
5
3
72
We got a DOCTOR IN THE LAB !!! 🧬🔬 congrats @SepidehTavakol2 on earning those 3 letters && congrats @SRouhanifard on your first PhD graduate!!
1
1
6
Daughter just laughed and said to me “boys can be scientists too???” 😂
1
1
25
Have you heard the news? Our alumna Samantha Johnson '21 made the @Forbes 30 under 30 Boston list for her robotic hand Tactile ASL Translational Use Machine (Tatum). Check it out: https://t.co/uw42ZTeyG0
0
1
4
Me realising it’s already august and I’ve procrastinated for too long
4
289
1K
As someone who just formed my committee, IMO a descriptive email should precede a meeting. Mine included 1) a brief introduction, 2) abstract-esque research description 3) how this PI's expertise would be beneficial. Everyone's busy; let's be time efficient
Not sure who is giving this guidance, but PhD students: we don't need to meet to discuss whether or not I should be on your thesis committee. Just send a description of what you do and why I might be helpful. I can decide based on that.
0
0
4
Nothing makes me trust a paper more than if it's written cautiously, tries hard not to overstate or over-interpret the data, openly discusses weaknesses & alternative explanations. Tell me all the caveats, understate the conclusions, remind me that your model is speculative.
6
43
393
From personal experience, @arjunrajlab is an awesome mentor!!! 🙌🏼🙌🏼🙌🏼
2
2
39
Me: I’m going to have a super productive day northeastern internet: you thought wrong
0
0
2
Our raptureFISH method is live! https://t.co/9EyjwZromq
@Yifang17957864
@JakeLPotts
@KeqingN
@CAMcCormick20 @NUBioE1 @ACS_Sensors 1/4
pubs.acs.org
Early detection of viruses can prevent the uncontrolled spread of viral infections. Determination of viral infectivity is also critical for determining the dosage of gene therapies, including...
4
11
39
petition to have journal submissions adopt the college admissions "common app" platform
0
1
3
I recently interviewed a strong candidate. She generously credited other researchers whose methods enabled her research. This created a strong positive impression about her. Deservingly crediting others does not diminish our contributions. ◼️It frames them in a helpful context.
7
18
206